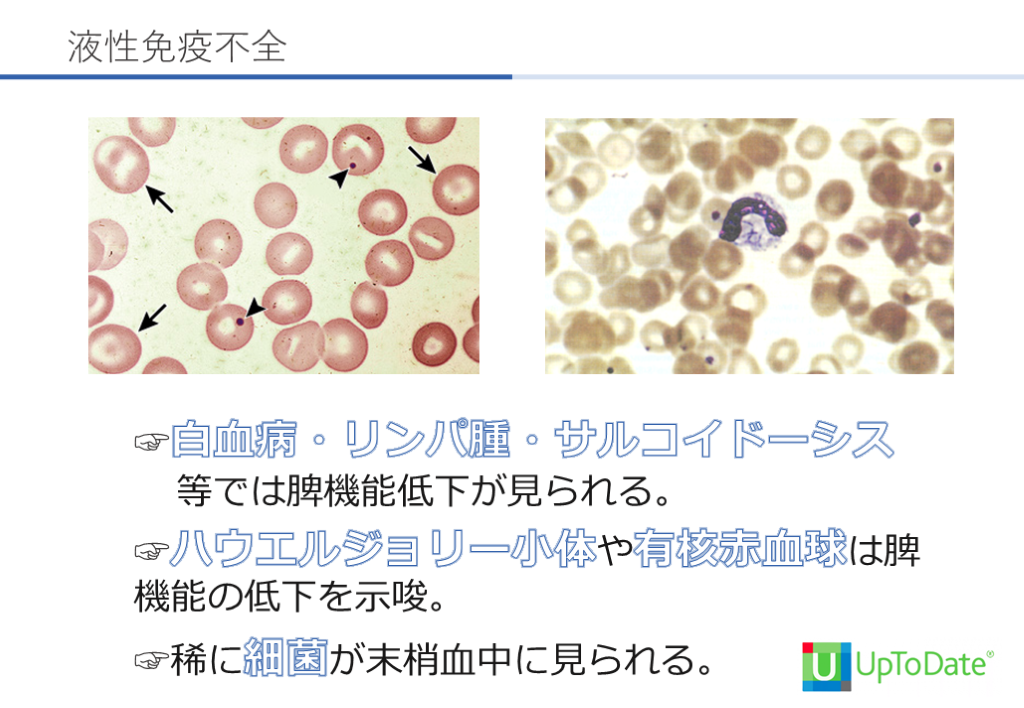

1/68
関連するスライド
初期研修医向けグラム陰性桿菌の基本
関川喜之
2621
22
「ミリしらからはじめる!」肺炎球菌ワクチン
松浦良樹
11070
54
はじまりの抗菌薬 サルバルサン
山口裕崇
10093
17
真菌感染症の基本
わかやま
38346
123
癌患者の感染症の基本
わかやま
Award 2025 受賞者
一宮西
15,738
84
概要
癌患者の感染症の基本です。がんセンターの感染症内科で教えていただいた内容を詰め込みました。
本スライドの対象者
医学生/研修医/専攻医/専門医
投稿された先生へ質問や勉強になったポイントをコメントしてみましょう!
0 件のコメント
わかやまさんの他の投稿スライド
病態生理で迫る臨床推論 ⑧
わかやま
17,028
67
グラム陽性桿菌 オーバービュー
わかやま
8,626
40
病態生理で迫る臨床推論③(開口障害) なんとなくのキーワード診断から脱却するために
わかやま
11,775
24
このスライドと同じ診療科のスライド
テキスト全文
癌患者の感染症の基本概念と構造異常
#1.
Infectious Diseases In Cancer Patients 一宮西病院 総合内科リウマチ膠原病内科 若山 裕人
#2.
がん患者の感染症 構造異常 バリア破綻 免疫不全 デバイス
#3.
癌患者の感染症 1 2 3 4 構造異常 バリア破綻 免疫不全 デバイス
癌患者におけるバリア破綻と免疫不全
#4.
癌患者の感染症 1 2 3 4 構造異常 バリア破綻 免疫不全 デバイス
#5.
解剖学的変化 原発巣と転移巣 管腔の狭窄 瘻孔形成 手術操作
#6.
癌患者の感染症 気管 閉塞性肺炎/膿胸 胆管 胆管炎/肝膿瘍/胆嚢炎 腸管 腸閉塞/穿孔/腹膜炎 尿路 腎盂腎炎/前立腺炎
閉塞性肺炎の診断と臨床的特徴
#7.
Ann Transl Med. 2019 Aug; 7(15): 357. 閉塞性肺炎
#8.
閉塞性肺炎 Ann Transl Med. 2019 Aug; 7(15): 357.
#9.
閉塞性肺炎 Ann Transl Med. 2019 Aug; 7(15): 357.
#10.
閉塞性肺炎 臨床症状と特徴 難治性、再発性の肺炎の際に想起する。 小細胞癌や扁平上皮癌等の中枢側の癌に多い。 診断と検査 感染は閉塞の遠位にあり、微生物の入手が困難。 造影CTは閉塞の特定に有用。 最終的には気管支鏡が必要となる。 Ann Transl Med. 2019 Aug; 7(15): 357.
手術部位感染症の種類と発生率
#11.
気管食道瘻 気管支胸膜瘻 膀胱膣瘻 膀胱直腸瘻 瘻孔形成しやすい悪性腫瘍
#12.
術後の感染症 ☞手術により大きく解剖が変化。 ☞術中の様子や術後の解剖学的に流れが滞り 細菌の増殖がないか。 ☞手術により再建方法が多岐にわたる。 ☞時期によって鑑別が大きく変化。
#13.
手術部位感染 皮膚表層SSI 切開部深層SSI 臓器/体腔のSSI 術後30日以内に発生した手術部位の感染症 切開部の皮膚、皮下組織に限局 感染は筋膜、筋層に達する 感染は臓器に達する
#14.
日本における手術部位感染症の割合 院内感染対策サーベイランス(JANIS 2022) 膵頭部切除 胃手術 大腸手術 冠動脈バイパス 股関節手術 膝関節手術 脊椎手術 4.2% 22% 7% 8% 1% 1% 3% 3%
消化器外科術後感染症の合併症と対策
#15.
予防投与に使用される抗菌薬の一覧 術後感染予防抗菌薬適正使用のための実践ガイドライン
#16.
消化器外科術後感染症
#17.
消化器外科術後感染症 〜食道〜 ☞縫合不全と肺炎が二大合併症である。 ☞リンパ節郭清による反回神経麻痺で誤嚥を きたすことがある。 ☞縫合不全から縦隔炎をきたしうる。 ☞ 12.6%が縫合不全、14.8%が術後肺炎をきたす。 臨外77(13):1446~1451 2022/Ann Surg. 2017 Mar;265(3):527-533.
#18.
臨外77(13):1446~1451 2022 a 縫合部位周囲の液体貯留 b 吻合部から漏出した造影剤 消化器外科術後感染症 〜食道〜
#19.
消化器外科術後感染症 〜胃〜 ☞縫合不全と膵液漏が問題となる。 ☞縫合不全があると断端のドレーンから胆汁 や食物が出てくる。 ☞縫合不全は術後5-7日後に好発する。 ☞縫合不全は1.1-2.5%にみられる。 臨外77(13):1446~1451 2022/Ann Surg. 2017 Mar;265(3):527-533.
婦人科術後感染症のリスクと予防
#20.
胃癌の術式 ドレーンは語る
#21.
消化器外科術後感染症 Infection volume 37, pages 522–527 (2009)
#22.
消化器外科術後感染症 〜大腸〜 ☞大腸手術は他の部位に比較してSSIの 発生率が高く10-30%と報告されている。 ☞腹腔内膿瘍は術後1ヶ月までいづれの 時期に発生しうる。 Colorectal Dis. 2022 Feb;24(2):239./外科感染症診療マニュアル ☞腹膜炎や腹腔内膿瘍をきたす。 ☞腸球菌、カンジダのルーチンのカバー はしない。
#23.
婦人科術後感染症 ☞微生物が皮膚からと膣からの上行性に侵入。 ☞複数菌感染が多く、GNR・腸球菌・B群連 鎖球菌のカバーが必要。 ☞子宮手術では1.4-6.3%、卵巣手術では0.6 -4.2%で術後感染をきたす。 Infect Dis Obstet Gynecol. 2015 Feb 18.
#24.
婦人科術後感染症 Infect Dis Obstet Gynecol. 2015 Feb 18.
呼吸器外科術後感染症の特徴と診療
#25.
呼吸器外科術後感染症 ☞閉塞性肺炎、膿胸、縦隔炎をきたす。 ☞インフルエンザ桿菌、肺炎球菌、緑膿菌、肺炎桿 菌、黄色ブドウ球菌、GNR全般と微生物が多彩。 ☞経気道的侵入か経皮的侵入かを意識して診 療する。 ☞気管瘻の有無を確認する。
#26.
呼吸器外科術後感染症 COPDの合併 気道の狭窄 人工呼吸器 ケモ/放射線
#27.
呼吸器外科術後感染症 外科感染症診療マニュアル
#28.
呼吸器外科術後感染症 外科感染症診療マニュアル
#29.
脳外科術後感染症 ☞髄液培養が最も重要であり抗菌薬投与前に採取する。 ☞複数の培養で1つのみコンタミの起きやすい 菌が出た際にはコンタミネーションを示唆。 ☞黄色ブドウ球菌・GNR・真菌は真の感染。 ☞症状のない患者の検体はコンタミネーションも多 い。 Clinical infectious disease Volume 64, Issue 6, 15 March 2017
#30.
髄膜炎 シャント感染 脳外科術後感染症 ・いづれも症状が乏しいことが多い。 ・髄液検査が正常でも否定ができない。 ・化学性髄膜炎との鑑別が難しい。 Clinical infectious disease Volume 64, Issue 6, 15 March 2017
脳外科術後感染症の診断と微生物
#31.
脳外科術後感染症 外科感染症診療マニュアル
#32.
脳外科術後感染の微生物 外科感染症診療マニュアル
#33.
癌患者の感染症 1 2 3 4 構造異常 バリア破綻 免疫不全 デバイス
#34.
バリア破綻 皮膚バリア バリア破綻⇨常在菌が侵入 癌患者の感染症 粘膜バリア
#35.
癌患者の感染症 Infect Dis Ther. 2017 Mar; 6(1): 69–83.
液性免疫不全のメカニズムと病原体
#36.
☞本来皮膚や粘膜(口/気道/消化管/尿路)は微生物から体を守っている。 ☞放射線、外科処置、医療機器により粘膜バリアは破綻する。 ☞バリア破綻している部位がないか意識して診療にあたる。 癌患者の感染症 Infect Dis Ther. 2017 Mar; 6(1): 69–83.
#37.
癌患者の感染症 1 2 3 4 構造異常 バリア破綻 免疫不全 デバイス
#38.
液性免疫不全 ☞ B細胞系による抗体を介した免疫機構。 ☞莢膜を持つ微生物の感染時に重症化する。 ☞ B細胞系の血液腫瘍、脾摘、リツキシマ ブ等によって液性免疫不全が見られる。
#39.
☞白血病・リンパ腫・サルコイドーシス 等では脾機能低下が見られる。 ☞ハウエルジョリー小体や有核赤血球は脾機能の低下を示唆。 ☞稀に細菌が末梢血中に見られる。 液性免疫不全
#40.
液性免疫不全患者で意識する病原体
細胞性免疫不全と関連する微生物
#41.
脾摘の適応 悪性腫瘍(卵巣癌播種・膵癌・結腸癌・胃癌・腎癌) 遺伝性球状赤血球症・ITP・AIHA 脾静脈血栓・脾膿瘍・脾腫瘍・脾膿瘍 不適合腎移植・CLL・HCL・骨髄線維症 脾梗塞・TTP・シックルセル病 ◯絶対的な適応 寒冷凝集症・ALPS・代謝疾患・肝硬変の血小板減少 △稀に適応 ×禁忌
#42.
細胞性免疫不全 CD4陽性T細胞(ヘルパーT細胞) CD8陽性T細胞(キラーT細胞) 細胞内寄生菌、S. aureus、真菌の免疫担当 ウイルス全般への免疫を担当
#43.
細胞性免疫不全 ☞プレドニン700mg以上がリスク。 ☞リンパ球系腫瘍、HIV、薬剤等で細胞性免疫の低下をきたす。 ☞多様な微生物による感染症をきたす。 症例から学ぶがん患者の感染症
#44.
Listeria Legionella Mycobacterium Nocardia Salmonella S. aureus LLMNSS 代表的な細胞性免疫不全時の微生物
#45.
細胞性免疫不全時の微生物 多様な病原体が原因となりうる。
#46.
特徴的な抗癌剤と抗体薬 液性免疫不全 細胞性免疫不全 粘膜障害 リツキシマブ ベンダムスチン テモゾロミド フルダラビン フルオロウラシル シクロフォスファミド イホスファミド カペシタビン タキサン系 プラチナ系 造血幹細胞移植 Infect Dis Ther. 2017 Mar; 6(1): 69–83.
#47.
特徴的な抗癌剤と抗体薬
化学療法による免疫抑制と感染症リスク
#48.
特徴的な抗癌剤と抗体薬 Clin Cancer Res. 2011 Aug 15; 17(16): 5473–5480. デモゾリミド+放射線 高悪性度脳腫瘍でCD4リンパ球低下をきたす (アルキル化薬)
#49.
化学療法とナディア① 白血球 赤血球 血小板 骨髄抑制期(ナディア) 一般的には7-14日 7日目 14日目 DLBCL (約21日サイクル) 抗癌剤 出血・感染症に注意が必要 R-CHOP A-CHP
#50.
化学療法とナディア② 7日目 14日目 ホジキンリンパ腫 (28日サイクル) 抗癌剤 28日目 21日目 A-AVD ABVD 好中球低下はそれほどひどくない
#51.
ナディアが深く長い 抗癌剤 21日目 急性骨髄性白血病 4-7日目 (約30日前後) 白血球 赤血球 血小板 化学療法とナディア③
#52.
好中球減少患者の注意点 ②通常見られない部位の感染症 ③重症感染症と急速な進行 ①症状や所見が乏しい 皮膚所見のない蜂窩織炎・膿尿のない腎盂腎炎・レントゲン陰性の肺炎 好中球減少性腸炎・肛門周囲膿瘍・粘膜傷害による菌血症 免疫正常者より進行が早く致死率が高い
#53.
好中球減少患者の菌血症時の死亡率 5% グラム陽性菌 グラム陰性桿菌 複数菌菌血症 緑膿菌菌血症 18% 13% 31%
#54.
irAE
癌を模倣する感染症の事例と注意点
#55.
irAE 重篤合併症が起こりやすい 腸炎・下垂体炎・皮疹 肺炎・筋痛・甲状腺↓・関節痛 Ann Oncol. 2016 Apr;27(4):559-74
#56.
56 イピリムマブ 二ボルマブ irAEが出現するまでの時期
#57.
irAE CMV腸炎 CD腸炎 腸結核 PCP その他の真菌 肺結核 ウイルス性肝炎 (CMV・HBV) ステロイド抵抗性のirAEを見たら・・ 腸炎 肺炎 肝炎
#58.
癌患者の感染症 1 2 3 4 構造異常 バリア破綻 免疫不全 デバイス
#59.
癌患者の感染症 CVポート 腎瘻・尿管ステント 胆管ステント VPシャント 乳腺インプラント 人工関節・人工骨
#60.
癌患者の感染症 ☞手術、医療処置、放射線、カテーテルが感染症に関連している。 ☞尿管、膀胱の病変は回腸での尿路変更や腎瘻が必要となる ☞中枢神経腫瘍は頭蓋内圧軽減のためのシャントが必要となる。 ☞頭頸部癌ではPEGチューブが必要となる。 Infect Dis Ther. 2017 Mar; 6(1): 69–83.
#61.
癌患者の感染症 1 2 3 4 構造異常 バリア破綻 免疫不全 デバイス ア ア
#62.
癌患者の感染症 5 周辺知識
#63.
腫瘍熱 ☞リンパ腫・肉腫・血液腫瘍・腎細胞癌で多い。 ☞発汗・紅潮が多く悪寒を伴うことは少ない。 ☞ナプロキセンは腫瘍熱が疑われる患者では 79.8%で有効であった。 ☞発熱は午前9時と午後5時に多く見られる。 Cancer Control. 2017 Apr;24(2):193-197.
#64.
薬剤熱 ☞薬剤の中止とともに解熱することで定義。 ☞発疹・好酸球増加・赤沈増加を伴う事がある。 ☞抗菌薬と抗癌剤は投与から発熱までが短い。 ☞投与してから抗癌剤は平均6.0日、抗菌薬は7.8日で発熱が起こるとされている。 Cancer Control. 2017 Apr;24(2):193-197.
#65.
癌を模倣する感染症 Supportive Care in Cancer volume 5, pages90–93 (1997)
#66.
癌を模倣する感染症 56歳男性の1年前からの咳嗽・体重減少 肺がん疑いの気管支鏡で結核PCR陽性 Respir Med Case Rep. 2015; 16: 45–47.
#67.